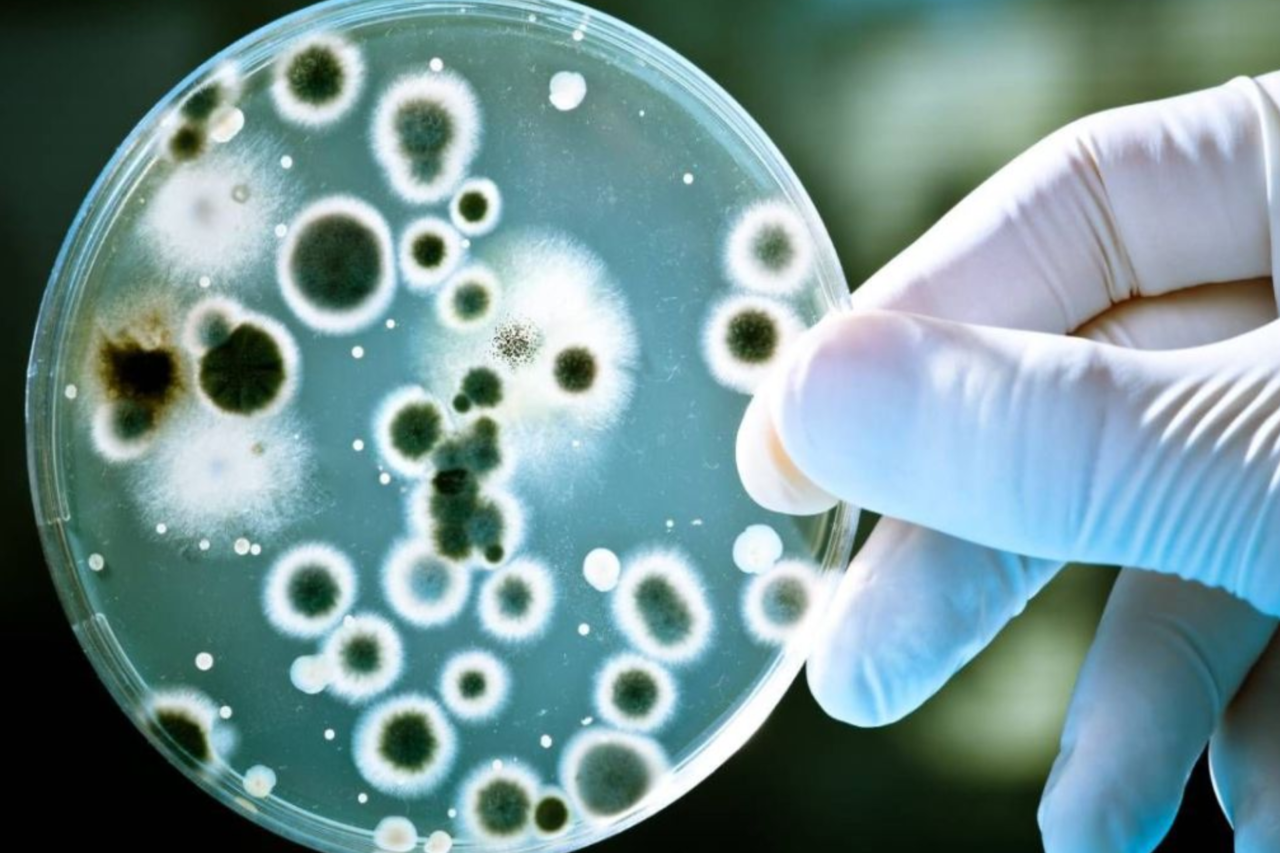
Bactéria preservada em gelo por cinco mil anos é identificada na Romênia 5 crys 3 3

Uma pesquisa científica realizada na caverna de gelo de Scărișoara, na Romênia, identificou uma cepa bacteriana preservada há aproximadamente cinco mil anos com resistência a antibióticos modernos. O estudo foi publicado em 16 de fevereiro na revista Frontiers in Microbiology e analisa as implicações ambientais e sanitárias da descoberta.
A amostra foi retirada de um núcleo de gelo extraído a cerca de 25 metros de profundidade na caverna, um ambiente considerado arquivo natural de material congelado que pode alcançar aproximadamente 13 mil anos. A camada específica analisada pelos pesquisadores foi datada em cerca de cinco mil anos. O microrganismo identificado recebeu a denominação Psychrobacter SC65A.3 e é adaptado a ambientes frios, não sendo capaz de infectar humanos.
Segundo os autores, aproximadamente 20% da superfície terrestre é composta por habitats congelados e de baixas temperaturas, o que torna relevante o estudo de microrganismos adaptados ao frio, especialmente diante das transformações associadas às mudanças climáticas. Esses ambientes funcionam como reservatórios naturais de diversidade genética e novas espécies microbianas.

Caverna de gelo de Scărișoara, na Romênia Foto: Reprodução/X
Resistência a antibióticos
Em laboratório, a bactéria foi exposta a 28 antibióticos utilizados no tratamento de infecções humanas. De acordo com os resultados, o microrganismo apresentou resistência a dez desses medicamentos, incluindo substâncias empregadas no tratamento de doenças como tuberculose e infecções urinárias. Entre os antibióticos testados estavam rifampicina, vancomicina, ciprofloxacina, trimetoprim, clindamicina e metronidazol.
Os pesquisadores destacam que a resistência observada não está relacionada à intervenção humana recente, mas a processos evolutivos naturais. O estudo reforça a hipótese de que genes de resistência antimicrobiana já existiam muito antes da utilização clínica desses fármacos.
O sequenciamento genético da Psychrobacter SC65A.3 revelou mais de 100 genes associados à resistência antimicrobiana e cerca de 600 genes ainda sem função conhecida, indicando elevado potencial de adaptação biológica.
Riscos associados ao degelo
Especialistas apontam que o aquecimento global e o consequente degelo de áreas congeladas podem favorecer a liberação de microrganismos antigos e, principalmente, de seus genes no ambiente atual. Conforme avaliação de pesquisadores envolvidos no estudo, o risco maior não está necessariamente em infecções diretas causadas por organismos ancestrais, mas na possibilidade de transferência genética para bactérias contemporâneas.

Esse fenômeno, conhecido como transferência horizontal de genes, permite que microrganismos atuais incorporem características de resistência, contribuindo para o surgimento de cepas mais difíceis de tratar. A circulação global de pessoas, animais e mercadorias amplia o potencial de disseminação desses genes em ambientes hospitalares, comunidades e cadeias produtivas de alimentos.
Monitoramento e estratégias de prevenção
Diante desse cenário, especialistas defendem a adoção de estratégias integradas dentro do conceito de Saúde Única, que considera de forma conjunta a saúde humana, animal e ambiental. Entre as medidas indicadas estão a vigilância em áreas com degelo acelerado, o monitoramento genético de solo, água e fauna, além do uso mais criterioso de antibióticos na medicina humana e veterinária.
Também são apontados como prioritários o investimento em novos medicamentos, terapias combinadas e vacinas, bem como programas educativos destinados a profissionais de saúde e à população para reduzir o uso inadequado desses fármacos.
Potencial científico
Apesar das preocupações relacionadas à resistência antimicrobiana, o estudo identificou aspectos considerados promissores. A análise do genoma da Psychrobacter SC65A.3 revelou a presença de pelo menos 11 genes com potencial para produzir substâncias capazes de inibir o crescimento de bactérias, fungos e vírus. Além disso, foram identificadas enzimas estáveis em baixas temperaturas.
Essas características podem contribuir para o desenvolvimento de novos antibióticos e aplicações industriais em ambientes frios, além de ampliar o conhecimento sobre a origem e a evolução natural da resistência bacteriana ao longo do tempo geológico.
A descoberta reforça a importância do monitoramento científico de ambientes congelados e do aprofundamento das pesquisas sobre microrganismos preservados em gelo antigo, especialmente diante das transformações ambientais em curso.
Fonte: ND+
Leia também:
- Caminhonete é completamente destruída pelo fogo no centro de Bernardo de Irigoyen
- O que o excesso de telas está fazendo com a visão das crianças?
- Antigas bibliotecas já tinham sistemas de catalogação



